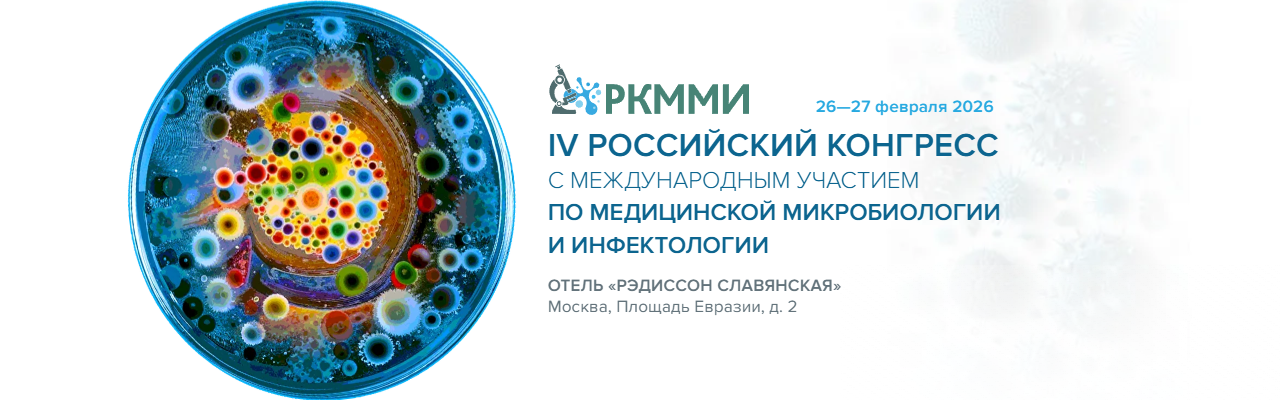

IV Российский конгресс по медицинской микробиологии и инфектологии
26 Февраля - 27 Февраля 2026
Москва, Площадь Европы, д.2, гостиница «Рэдиссон Славянская»
Приглашаем вас принять участие в Третьем Российском конгрессе по медицинской микробиологии и инфектологии, который состоится26-27 февраля 2026 года.
Организатор: ФЕДЕРАЦИЯ ЛАБОРАТОРНОЙ МЕДИЦИНЫ
Веб-сайт мероприятия:https://rcmmi.ru/

 Русский
Русский  Deutsche
Deutsche  Uzbek
Uzbek  English
English